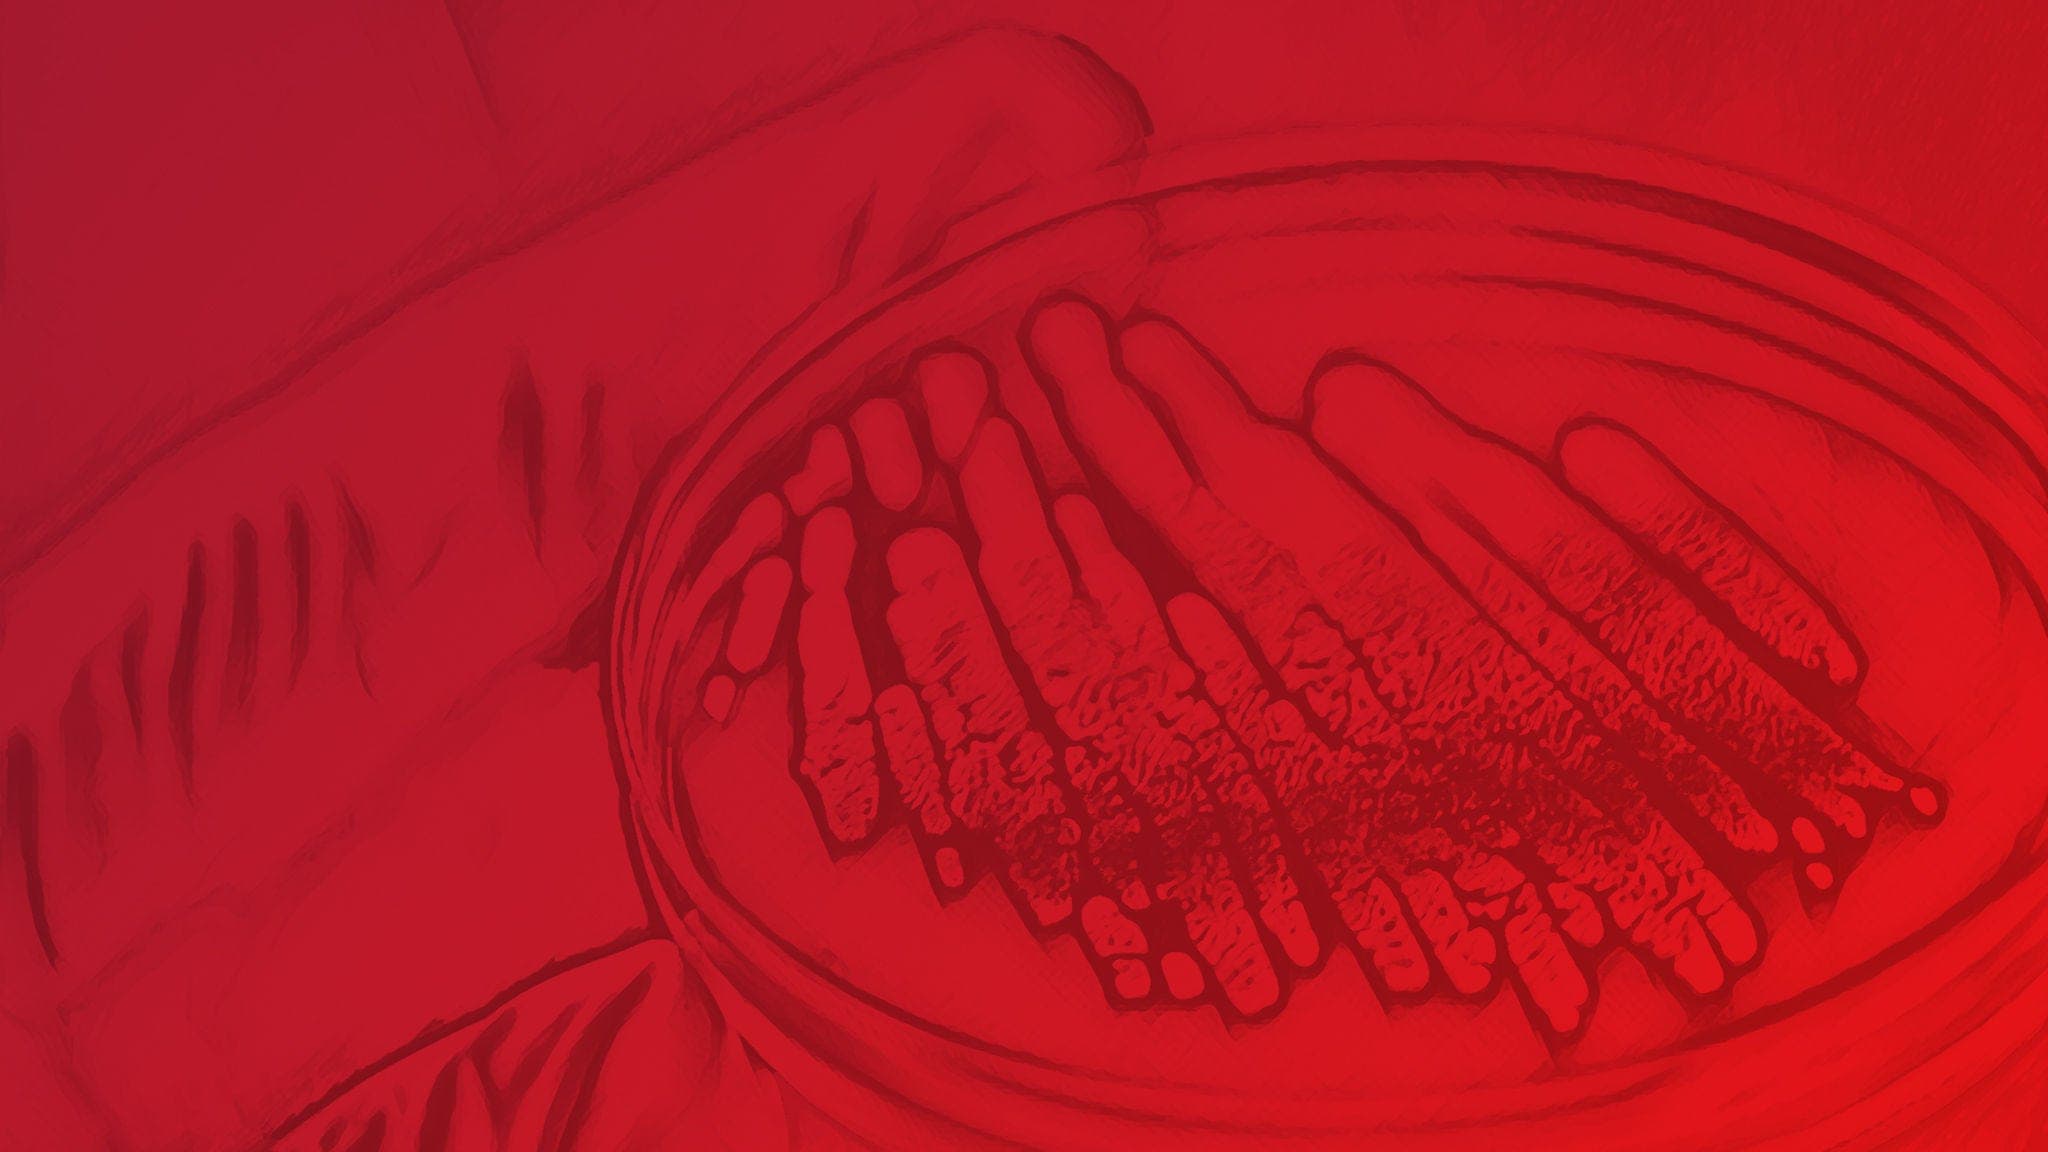
Antibiotics

- Top Categories
- Cell Culture Chemicals
- Protein Biology
- Molecular Biology
- Related Resources
Top Categories
To simplify your shopping experience, we're consolidating the Acros Organics™, Alfa Aesar™, and Maybridge™ brands under the Thermo Scientific™ brand.
Featured Products
Catalog Number 15684018
Catalog Number 15493429
Catalog Number 10306983
Catalog Number 10396820
Catalog Number 15485089
Catalog Number 15450677
Catalog Number 15493409
Custom and Bulk Chemicals
Cell Culture Chemicals
Chemical Categories
Discover cell culture chemicals that support you through every stage of your workflow.
Protein Biology
Chemical Categories
Find chemical tools and reagents for your analysis and manipulation of complex protein molecules.
Molecular Biology
Chemical Categories
Whether you’re delving into DNA sequencing, gene expression, or cloning, our products are designed to deliver exceptional accuracy and efficiency.